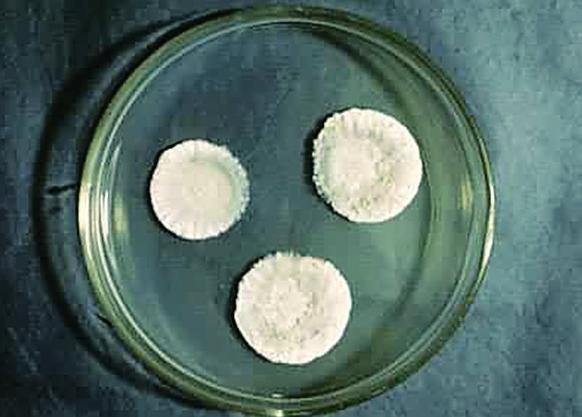

目录
酿醋古技
醋称谓的演变,从一个侧面反映了酸性调料的物料多源性和它们表现形态和制造技术的多样性。从酸酱到酸汁醋这一发展过程是复杂和渐变的。假若以酒为原料,只需其在较高温度下,让醋酸菌催化就可获得液态醋。假若以单糖类物质发酵制醋,也需先制成酒,再氧化成醋。假若以谷物为原料,其酿造过程和工序就更为复杂。不管以什么为原料,采取什么技术,其方法的核心依然离不开上述的酿酒制醋的科学原理,即包括一个系统工程:多糖变单糖的糖化工序、单糖变酒的酒化工序、酒变醋的醋化工序。
(注: 《四民月令校注》书影)
从现存的史料来看,描述制醋工艺的文献极少。《九经》中,醯字虽然常见,却没有讲述醯的具体制法。东汉崔实所著的《四民月令》中倒是把制酢列入农事之一,但只有一句话:“四月四日作酢,五月五日亦可作酢”。没有谈酢的制作技术。著于东汉年间的《神农本草经》把酸酱列入中品药之中,它说:“酸酱,味酸平,主热烦满定志益气,利水道产难吞其实立产,一名醋酱,生川泽。吴普曰改浆一名酢浆。”可见此书讲的主要是醋果浆。在《史记·货殖列传》中,曾记述说:“通邑大都,酤一岁千酿,醯酱千瓨,酱千甔。……蘖曲盐豉千苔……此安比千乘之家,其大率也。”酤即卖,瓨为长颈大腹的陶瓶,甔为容量为一石的陶制大瓮,苔为瓿,是容量为六升陶制容器,这段记载表明在汉初,享用醯已推广到平民百姓,在通邑大都这个地方,已有专门生产和经营醯、酱及豆豉的商人,他们的财富不比当时的“千户”(官职)差。由此可见,汉代醯的生产已成为社会生产的一个组成部分,尽管规模和产量不如酒,但已成为生活的常用调味品。
在现存的古代文献中,比较集中地介绍早期制醋技术的资料算是《齐民要术》,它一共介绍了当时的23种制醋法。从这些制醋法所用的原料来看,有黍米、秫米、小麦、大麦、大米、粟米、面粉、大豆、小豆、酒醅、酒糟、败酒,粟糠、蜂蜜等,绝大多数谷物已包括在内,前15种制酢法大多是流行在北方地区的制醋法,收录自《食经》的8种制苦酒法是当时流行在南方地区的制醋法,可以认为《齐民要术》所反映的制醋技术在当时是较全面的。用谷物酿制食醋,糖化、酒化、醋化三个发酵过程在同一醪液中进行,主要依靠的是酒曲所携带的微生物,下面先探讨当时相关曲的制造。
考察15种制酢法可以发现,制酢的曲或其他配料不尽相同。其中有8种采用麦



酿醋中的曲
从制醋的工艺流程来看,酿醋必须先酿酒,而酿酒必先制曲。酿酒主要采用酒曲,酿醋用的曲与酿酒之曲略有不同。酿酒偏爱块曲,而酿醋喜好散曲,常用的黄衣曲就是从散曲中分化和筛选出来的。块曲上所繁殖的主要霉菌以根霉、酵母菌等为主,而散曲上繁殖的微生物主要以米曲霉等霉菌为主。根霉的糖化能力比米曲霉强,而酵母菌又是酒化的主要菌种,所以酿酒通常选用以根霉为主的块曲。米曲霉中含有多种酶类,其中糖化型淀粉酶和蛋白酶较强,蛋白酶能将蛋白质分解为氨基酸,而氨基酸则是食醋中不可缺少的呈味成分,所以米曲霉是酿醋的主要菌种。黄衣曲就是让蒸熟的整粒的麦繁殖大量的菌丝体及呈黄色孢子的米曲霉。所以,含根霉、毛霉、酵母菌较多的块曲适用于酿酒,而含米曲霉和多种蛋白酶较多的散曲则更适于制醋。
(注: 米曲霉)
当时的“鞠”仍是以米曲霉为主的散曲,只有空气充分的散曲,米曲霉才能结得旺盛如尘的黄色孢子。“黄衣”可能是我国古代劳动人民对培养米曲霉的最早描述,因为限于当时的科技水平,人们不可能直接看到霉菌的分生孢子和菌丝,却可以看到大量孢子囊所呈现的黄色。
关于米曲霉的培养,即黄衣曲的制备,贾思勰《齐民要术》中是这样记述的:
从记述中可以看出,麦曲培养条件的控制在制曲过程中是很重要的。首先,文中强调了制曲的季节——“六月中”,又如其他曲的制作“作黄蒸法:六七月中”等。曲的培养主要是依靠自然界中的微生物通过天然接种于曲料上,进行培养取得大量酿造所需的有益微生物。而自然界中微生物的分布情况随季节的不同而变化,一般春秋季酵母多,夏季霉菌多。这使人们在长期实践中得知,春末夏初到仲秋季节是制曲的最佳时期,即“伏天踩曲”。在这段时间里,环境的温度和湿度比较高,有利于曲的培养和条件的控制。而米曲霉的生长繁殖需要比较高的温度和湿度,农历六七月气温较高,湿度也较大,空气中霉菌、酵母等的数量也较多,选择这个时期制曲是有科学道理的。
所制备的曲的质量优劣,主要是取决于曲入室后的培菌管理,曲室的温度、湿度和通风情况对于霉菌的生长繁殖是很关键的。《齐民要术》卷七中已介绍对曲室的要求“屋用草屋,勿使瓦屋”;“闭塞窗户,密泥缝隙,勿令通风”。在霉菌生长的初始阶段,曲要保温,密封曲室防止透气,就起了保温作用。草屋曲室较瓦屋好,不仅保温效果好,而且有自动调节湿度的作用,还可以避免产生冷凝水。制备黄衣曲的前一天要求在曲室的地上铺上一层薄薄的薍叶,这样做也是起保温作用,便于霉菌孢子的繁殖。“候麦冷,以胡枲覆之”,指由于此时霉菌的孢子需要水分及温度以发芽,用胡枲盖在麦上,是为了保温,便于菌丝正常发育。七天后待霉菌生长遍结孢子,便可取出,在阳光下曝晒干燥,以便保存备用。
另外,酸度的控制也是黄衣曲制备过程中的重要环节。“于瓮中以水浸之,令醋”,是说将小麦或麦粉进行浸泡,让其进行乳酸发酵,使它们变酸。米曲霉的生长是耐酸性的,所以“令醋”的措施就可以促进米曲霉的繁殖,从而抑制一部分不耐酸性的微生物,尤其是细菌的生长。当时人们制备黄衣曲,实际上就是培养米曲霉及其他有益微生物的混合物。这里的“衣”其实是指霉菌的繁殖分布,“黄衣”的“衣”是曲霉繁殖后的菌体及所结的孢子。“皆仰其衣为势”中的“势”,是当时米曲霉等霉菌中的酶及其活力的称呼。文中还指出山东齐郡的人喜欢顶风把黄衣簸掉是错误做法,能指出这一错误,说明当时人们已意识到霉菌孢子在酿造工艺中的作用。
(注: 《齐民要术》中黄衣的生产工艺流程)
《齐民要术》中记述的神酢法是采用黄蒸作为制醋的曲,黄蒸也属于米曲霉散曲,但它与黄衣不同,是用带麩皮的面粉做的曲。其工艺如下:“作黄蒸法:六七月中,

(注: 黄蒸生产工艺流程)
用黄蒸制醋,除利用米曲霉的酶系进行糖化及蛋白质分解外,还利用生产黄蒸时所产生的乳酸菌分解生成多种有机酸来提高食醋的风味,同时还可以利用麩皮中的蛋白质转化为氨基酸来调整食醋的营养和风味。在制醋中较少采用笨曲,笨曲近似于现在的大曲。这种曲主要以根霉为主,酶系中蛋白酶较弱,因此成品中氨基酸的含量较低,醋的风味就逊色些。当人们遵从先酿成好酒,再酿制成醋的思路,故在分段发酵中依然使用笨曲。采用以米曲霉为主的散曲制醋的方法中,回酒做酢法是同时加入酒醅的制醋法。这种方法是将黄酒的发酵醪或将成熟并已酸败的醪改酿成醋的方法,这种方法要重新加入曲、米等配料,使醋酸菌进一步繁殖,促使酸化,将酸败的酒酿成醋。
制酢法
贾思勰在《齐民要术》中介绍的15种制酢法,大多是当时黄河中、下游地区的制醋方法。这些方法几乎全部都是液态发酵,即从原料糖化到醋酸发酵的全过程都是在液态下进行的。在这种糖化、酒化、醋化同时进行的复式发酵中,不存在糖度和酒精度过大的问题,而是醋酸发酵势头逐渐加大,直到食醋发酵的成熟和生产的结束。下面先讲述《齐民要术》中几种主要的制酢法的工艺要点。
《齐民要术》中以谷物为原料的制酢工艺有八项之多。其中以粟米为原料制酢的方法有三则。作大酢法之一:
(注: “作大酢法”工艺流程)
后两种方法大同小异,它们都是以粟米为原料,麦



秫米神酢法中,麦

在其二的“秫米酢法”中,出醋率较高,除了原料品种和用曲性能的原因外,还有一个特点值得注意,那就是使用了粟米醋浆,所谓醋浆即是用粟米制作成的乳酸菌母液,这里的醋实际上是酸的意思。
关于醋浆,文中是这样写道:入五月则多收粟米饭醋浆,以拟和酿,不用水也。浆以极醋为佳。这种做法的实质是扩大培养乳酸菌。制醪不用水,而用此酸浆,既接种乳酸菌,又可调节发酵醪的pH,使之适合于酵母的繁殖,并利用乳酸菌的抑菌作用,保证酒精发酵的进行,这是“以酸抑酸”技术的应用。和酿酒技术中的酸浆应用一样,是酿造技术上的一大进步,此外发醪液中,乳酸的存在也改善了食醋的风味。
《齐民要术》中的大麦酢法是以大麦为原料生产食醋的最早文献,原文如下。
(注: “大麦酢法”的工艺流程)
文中所说的“造”相当于“舂”字的含义,就是今日的精白,即将大麦的硬外皮,胚芽或麩层去掉,精白程度越好,淀粉含量就越高,而蛋白质、脂肪、灰分则少。大麦只要适度精白,残留的胚芽及麩层,蛋白质、灰分、生长素等较多,有利于微生物发酵作用。
大麦酢法中还提到白醭这样一个技术问题。由于制醋大都在夏天进行,又多属稀醪发酵,成熟较快。在这过程中,气温高,杂菌极易侵入,稍不注意,即有白醭生成,白醭是一种产膜酵母,不同于酿醋中出现的“衣”。文中所说的衣是指醋酸发酵旺盛时所产生的菌膜。这种菌膜可任其自然生长,当它老熟而失去产酸能力后,会自然地从发酵醪表面下沉。菌膜下沉即标明酿醋己成熟了。白醭则不一样,它会消耗醪液中的醋酸和含氨成分,同时由于它的菌体自溶,会产生恶臭,从而影响了成品醋的质量。故贾思勰说“生白醭则不好”,怎样防范呢?“发时数搅,不搅则生白醭”,假若已有白醭生成,则可“以棘子彻底搅之”。这种防范和补救的方法都是很科学的,因为产膜酵母是好气性菌,无法接触空气则难以繁殖,故可以通过搅拌,特别是加棘子彻底搅拌,让已生成的白醭菌孢沉入醪液中,使其与空气隔绝,无气而繁殖被抑制。对“衣”和“白醭”这两种具有截然不同特性的两类微生物,先人已能采取不同的方法来处理,这是酿醋工艺中的重要成果,是通过长期实践和细心的科学观察而取得的。
烧饼作酢法,实际上是利用面粉为原料,其工艺如下。
(注: “烧饼作酢法”的工艺流程)
这种利用烧饼的制酢法实际上是模仿酿酒中的“酘”法,即将原料烧饼分批投入已将麦
回酒酢法、动酒酢法都是以酒为原料的制酢法,其工艺如下:
回酒酢法是利用酿酒不正常酸败的酒醪进行制醋的工艺。由于发酵不正常,糖化不完全,可能还残存淀粉,因而人们采取了补充糖化力及酵母,同时加“井花水一石,粟米饭两石”,以降低酸度,补充微生物繁殖所需营养源。发酵的要领是将粟米饭“掸令冷如人体,投之,杷搅,绵幕瓮口,每日再度搅之”。醋酸菌是喜氧型的菌种,繁殖过程需要大量氧气,于是需要每天打耙。
(注: “回酒酢法”的工艺流程)
动酒酢法用的原料不是酒醅,而是已变酸的酒。首先是加水稀释,稀释后的酒有利于醋酸发酵。然后是在日光下暴晒,下雨时要盖,勿令雨水进入,晴天再去盖继续晒,七日后开始产醋酸,即使有臭味或菌衣生成,也不移动或搅拌。数十日后,醋成,菌衣自然下沉,醋反而特别香美。
神酢法是利用麦麸为原料,以黄蒸为糖化发酵剂而生产的麸醋。其生产工艺流程如图所示。
(注: 神酢法工艺流程)
由于古代精白加工技术尚落后,麦麸中含有较多的淀粉,淀粉分解后又产生较多的五碳糖类,发酵酿醋中不仅赋予鲜艳的褐色,而且生成某些特殊的香气。古人较早就认识到麦麸非常适合酿醋,故贾思勰在文中作了较详细的介绍,应用麦麸酿醋的方法后世一直沿用下去,成为酿醋工艺的一个重要分支。至今仍享有盛誉的四川保宁醋就是这一传统工艺的产品代表。
这种方法的特点之一是不用笨曲或麦
作糟糠醋法是利用黄酒糟的一种制醋工艺。一般是将酒糟与谷糠、砻糠拌和进行固体发酵,不加任何曲料和醋醅,单纯借助于酒糟的剩曲余热发酵酿成。其工艺方法具有以下特点。其一,室内麦秸保温酿造。原料配经是“酒糟、粟糠各半”。加糠可以使发酵醅疏松,通气,促进醋酸发酵。对原料粟糠的质量也有一定要求,“粗糠不任用,细则泥,唯中间收者佳”,以粗细适当者为好。制醅时酒糟及粟糠“必令均调,勿令有块”。其二,发酵的方法独具特色,之后发展成固态的“回浇发酵法”。这种制醋法是每天舀取竹箅中汁液浇到醋醅上,供给醋酸菌以氧气,促进酒精氧化成醋,同时达到降低醋醅温度的效果。“三日后糟热,发香气”是醋酸发酵旺盛的象征,如不采取浇淋的工艺,势必温度不断上升,最后导致“烧醅”。先人巧妙地采取这种浇淋醋液方法,解决了固态醋酸发酵需氧及降温的难题。其三,浇完质量浓醇的头淋醋之后的醋醅仍含有大量食醋,于是继续浇淋,“更汲冷水浇淋,味薄乃止”。并嘱说:“淋法,令当日即了”,以防变质。采取这样的工艺成熟较快,夏七日,冬二七日,尝醋极甜美。欲得成熟优质之产品,则是“其初挹淳浓者,夏得二十日,冬得六十日”。经过这种多次浇淋,不仅可以获得质量好的醋,而且也解决了固态发酵后怎样将固液分离,取得液态醋的技术难点。这种方法不需翻倒醋醅,节省劳力,故很快被推广并流传下来,今日著名的江苏镇江恒顺香醋就是继承、发展这种工艺的成果。
总之,通过贾思勰对上述15种制醋工艺的客观介绍,不难发现,北魏时期,在长期的制醋实践中,先民不仅掌握了食醋及其酿制技术的知识,而且也摸索到一些制醋过程的变化规律,积累了经验,并能较好地运用某些技能,以便获得香美醇厚的食醋。下面从科学技术的视角认识当时制醋工艺的科学技术内涵。
1.原料的处理。不同的制醋法选用了不同的原料,釆用不同的工艺流程,其目的就是保证发酵过程顺利进行。
2.发酵水分的控制。贾思勰强调加入适量的水是发酵成功的首要条件。水是制醋过程中微生物活动存在的必要条件之一,只有在水分充足的环境中,原料中的有效成分才能最大限度地溶出,才能最大限度地通过生化反应生成食醋的有效成分。从生产的角度看,必须选择一个合理的加水比。
3.温度的控制。由于微生物的生长发育是一个极其复杂的生物化学过程,这种过程需要在一定温度范围内进行,所以温度对微生物的整个生命过程都有极其重要的影响。根据微生物学知识,制醋过程中的温度控制,一般指糖化、酒化和醋化阶段的最适温度。通过温度的控制来促进有益微生物的生长,抑制或消灭有害微生物的发育。对温度的控制包括三个方面,一是气温,二是品温,三是适时搅拌。
4.酸度的控制。由于微生物都是由蛋白质组成的,因此它们的生长和作用都需要适宜的酸碱度范围。不同的微生物要求的pH值不同,大多数细菌最适pH值接近中性或微碱性,酵母和霉菌的最适pH值趋向酸性,因此在发酵过程中酸度的控制是十分重要的。适宜的酸度范围有利于曲霉的生长,还可以加强淀粉酶的糖化活动。在酒精发酵过程中不同的pH值可以使发酵的产物不同,pH值对酵母菌的生长影响也很大。酵母菌只能在微酸性的条件下生长并进行正常的酒精发酵,发酵时一般要求pH值为4.2~5.0,超出这一酸度范围就不适宜酵母菌的繁殖。
5.酒精度的控制。在酒精发酵阶段控制生成的酒精度数,也是酿制好醋的一个关键。现代酿醋工艺中,乙醇的含量在7%左右,如含量过高则不利于醋酸菌的繁殖。
6.卫生条件的控制。15种制酢法中每种制醋的全过程大多十分讲究器具和用水的洁净。特别在发酵过程中,大多制酢法的容器中都要蒙上一层丝绵,既保持瓮内空气流畅,又防止灰尘杂菌的进入。
7.成醋的保存方法。保存成品醋应放在避光阴凉的地方。有必要还可在瓮口盖上盆并用泥封住,是为了防止空气中的杂菌渗入瓮内而使成醋变坏。
上述传统制醋工艺中的技术要素,对现代制醋工艺产生了深远的影响,其中的许多经验和方法至今仍有借鉴作用。
苦酒工艺
贾思勰引自《食经》的8种苦酒制法与上述15种制酢法不完全一样。大豆千岁苦酒法、小豆千岁苦酒法和小麦苦酒法都是以含乙醇的物质为原料,而不用任何曲或酵母。水苦酒法和卒成苦酒是以含淀粉物质的谷物为原料,加入曲来促成发酵制醋。而蜜苦酒法和外国苦酒法则是以含糖物质为原料,通过酒化和醋化过程制醋。
从工艺方面来说,蜜苦酒法最能体现当时南方制醋的特点。《齐民要求》中是这样叙述的:“蜜苦酒水:水一石、蜜一斗,搅使调和,密盖瓮口。著日中,二十日可熟也。”这种制醋方法,直接将水和蜜调拌,在高温季节放在日光下暴晒,利用空气中的酵母及醋酸菌进行酒精发酵和醋酸发酵而酿取食醋,这是靠自然条件而制取食醋的方法。将它与其他7种苦酒法比较,会发现这8种苦酒法彼此之间既有相同之处,又存在着差别。
做大豆千岁苦酒法,由于豆类含有多糖,不能直接用来制醋,所以在制醋过程中要先将大豆浸泡在水中,捞出来后煮熟再放在太阳下暴晒。煮熟的目的是使大豆淀粉发生变性,而暴晒是为了使豆失去水分。晒干后再用酒醅浇灌大豆,是为了把大豆中可溶于酒精的有效成分溶解出来,以增加醋酸的含量,这也利于醋酸菌的繁殖。做小豆千岁苦酒法和做小麦苦酒法的原理也是如此,这3种制醋法都是直接经过乙醇氧化而制取醋。
水苦酒法的制作中有浸泡粗米过夜的过程。浸米的目的是为了保证淀粉原料吸足水分,让水分不只是附着于淀粉的颗粒表面,而是要进入淀粉颗粒内部,使淀粉颗粒的巨大分子链由于水解作用而展开,便于在常压下蒸煮时能在较短时间内就糊化透彻。
米浸泡一夜就会变酸,米在酸性溶液中浸泡,可除去外部的一部分蛋白质,使酿成的醋风味醇厚。将浸米汁倾入瓮中做醋,是因为浸米后的泔水在制醋过程中起了酸浆的作用。泔水在发酵过程中不但可以调节发酵液的酸度,而且可促使乳酸菌进一步分解某些蛋白质类的有机物为氨基酸。
卒成苦酒法的制醋过程中,首先将曲烧至黄色,是为了将曲的表面杂菌消灭。“二日便醋”实际是酸化的过程,即等料发酸后再拌入粟米饭进一步发酵制取成醋。对于这个工艺,贾思勰曾亲自做试验,品尝后认为“直醋亦不美”。在经过“以粟米饭一斗投之,二七日后,清澄美酽”的加工后,此醋的质量才有所提高,与“大醋”的风味差不多。
(注: 乌梅)
乌梅苦酒法的工艺比较特殊,与其他7种苦酒做法不大相同。此法是直接采用苦酒浸泡乌梅肉数日,目的是让醋酸进入梅肉中去,把其中的糖类、果酸等成分溶解出来,进入醋液而提高食醋的风味。此醋类似于现在的固体醇。在此工艺中由于采用了已经酿制的苦酒,所以无需再经过生化反应来制取醋液了。
以上8种苦酒法中大多数工艺在最后工序中强调用布密盖瓮口,这样做一是为了保证发酵过程的反应完全,二是为了严防杂菌的侵入。
在发酵方式上,8种苦酒制法都是采用类似于现代的液体发酵法,这也是当时南方制醋的一个特色。液体发酵是指酿醋的主要过程都是在液体基质中进行,这种方法以酒液为原料,通过酒液同空气接触而使乙醇氧化成乙酸(醋酸),待酒精度降到一定程度时,即告成熟。贾思勰记述的前15种北方制酢法,有些是采用类似于现代的固态发酵法。固态发酵法是以粮食为主要原料,加水拌匀后蒸熟,如用米为主料,经蒸熟成饭后,冷却至体温,再经曲的糖化,酵母的酒精发酵,最后再进行醋酸发酵。固态发酵法最后采用加水淋醋的方法而获取醋液。淋醋是制醋过程中的最后一道工序,这一过程主要是使醋酸溶于水,再经过过滤和煎煮来清除杂质,以保持醋的纯净度,防止沉淀。蒸煮后,便密封贮存。
以上23种酢法,由于地域不同和原料差异,采用不同的发酵糖化剂和不同工艺,反映出当时的人们仍在通过自己的实践,探索多种制醋的良方。贾思勰所记载的23种制醋法不仅反映了当时我国劳动人民经过长期的生产实践,已经掌握了较丰富的生物化学知识,而且基本上形成了现代酿醋工业的技术体系,提出了一些极有参考价值的制醋工艺的科学道理。①在动酒酢法中提出了“衣生”和“衣沈”的概念,明确提出酒精转化为醋酸是醋酸菌(衣)的作用,并进一步指出“衣”是生物。②秫米酢法中提出的酸浆代替水拌料,这是早期利用天然的乳酸菌进行发酵的一种方法。③在烧饼做酢法和做大酢法的“又法”中进行分批加料的操作,起到扩大培养微生物的作用。这种方法是当时酿酒“酘”法在酿醋上的应用,也是现代酿醋技术“流加法”的开端。④制酢法的过程中提出了“掸令小暖如人体”的控制品温界限的标准,这一温度标准虽然粗略,但它的提出却是非常宝贵的。⑤做糟糠酢法、酒糟酢法和做糟酢法等的工艺中出现了用谷物做原料进行固体发酵酿醋,这种酿醋方法,对现代酿醋工艺产生了较大的影响。